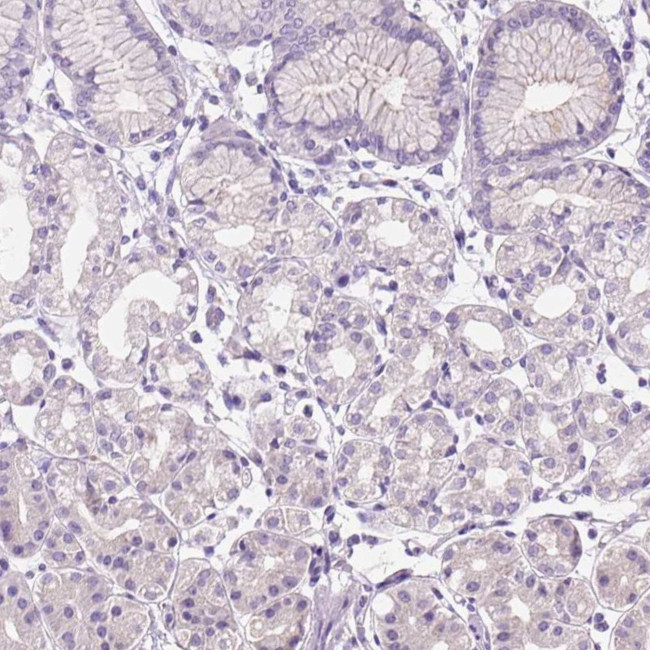
Claudin 17 Antibody in Immunohistochemistry (Paraffin) (IHC (P))

Search
Invitrogen
Claudin 17 Polyclonal Antibody
{{$productOrderCtrl.translations['antibody.pdp.commerceCard.promotion.promotions']}}
{{$productOrderCtrl.translations['antibody.pdp.commerceCard.promotion.viewpromo']}}
{{$productOrderCtrl.translations['antibody.pdp.commerceCard.promotion.promocode']}}: {{promo.promoCode}} {{promo.promoTitle}} {{promo.promoDescription}}. {{$productOrderCtrl.translations['antibody.pdp.commerceCard.promotion.learnmore']}}



Please note: We are reviewing Western blot images included in the antibody testing data in our catalog, including those provided by third parties. Unless expressly labeled or annotated as “raw-unedited”, Western blot images included in the antibody testing data in our catalog may have been edited, optimized or otherwise adjusted for presentation.
产品信息
PA5-83800
种属反应
宿主/亚型
分类
类型
抗原
偶联物
形式
浓度
规格
纯化类型
保存液
内含物
保存条件
运输条件
RRID
产品详细信息
Immunogen sequence: CNRKKQGYRY PVPGYRVPHT DKRRNTTMLS KTSTSYV
Highest antigen sequence indentity to the following orthologs: Rat - 59%, Mouse - 62%.
靶标信息
Claudin 17 (CLDN17) is a member of the claudin family of proteins, characterized by their involvement in the formation of tight junctions, which are crucial for maintaining the selective permeability barrier in epithelial and endothelial cell layers. CLDN17 is located on chromosome 21q22.11 and encodes a transmembrane protein that contributes to paracellular permeability regulation. This protein is associated with facilitating the passage of ions and small molecules between cells, playing a vital role in maintaining cellular homeostasis and tissue integrity. Recent studies have implicated claudin 17 in tumorigenesis, particularly in hepatocellular carcinoma, where its overexpression is linked to a more malignant phenotype and poor prognosis through mechanisms such as the Tyk2/Stat3 signaling pathway. The dysregulation of claudin 17 and its role in cancer highlight its potential as a biomarker for diagnosis and prognosis, as well as a target for therapeutic interventions aimed at modulating tight junction integrity and cellular interactions in cancerous tissues.
仅用于科研。不用于诊断过程。未经明确授权不得转售。
篇参考文献 (0)
生物信息学
蛋白别名: Claudin-17; MGC126552; MGC126554; UNQ758
基因别名: CLDN17; UNQ758/PRO1489
Entrez Gene ID: (Human) 26285